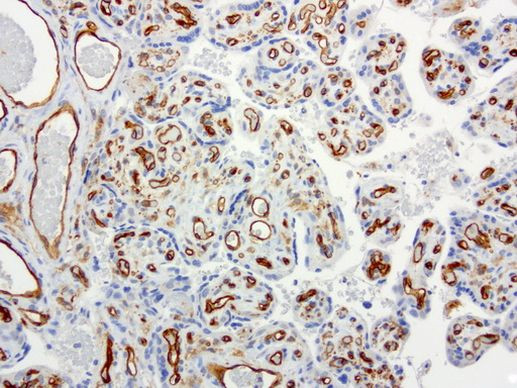
PECAM1 Antibody in Immunohistochemistry (Paraffin) (IHC (P))

Search
OriGene
PECAM1 Monoclonal Antibody (UMAB30), UltraMAB™
{{$productOrderCtrl.translations['antibody.pdp.commerceCard.promotion.promotions']}}
{{$productOrderCtrl.translations['antibody.pdp.commerceCard.promotion.viewpromo']}}
{{$productOrderCtrl.translations['antibody.pdp.commerceCard.promotion.promocode']}}: {{promo.promoCode}} {{promo.promoTitle}} {{promo.promoDescription}}. {{$productOrderCtrl.translations['antibody.pdp.commerceCard.promotion.learnmore']}}
图: 1 / 13
PECAM1 Antibody (UM500030) in IHC (P)













产品信息
UM500030
种属反应
宿主/亚型
分类
类型
克隆号
抗原
偶联物
形式
浓度
纯化类型
保存液
内含物
保存条件
运输条件
靶标信息
CD31 (platelet endothelial cell adhesion molecule-1, PECAM-1) is an inhibitory coreceptor involved in regulation of T cell and B cell signaling by a dual immunoreceptor tyrosine-based inhibitory motif (ITIM) that upon associated kinases-mediated phosphorylation provide docking sites for protein-tyrosine phosphatases. CD31 is expressed ubiquitously within the vascular compartment and is located mainly at junctions between adjacent cells. N-terminal Ig-like domain of CD31 is responsible for its homophilic binding, which plays an important role in cell-cell interactions. CD31 is a multifunctional molecule with diverse roles in modulation of integrin-mediated cell adhesion, transendothelial migration, angiogenesis, apoptosis, negative regulation of immunoreceptor signaling, autoimmunity, macrophage phagocytosis, IgE-mediated anaphylaxis and thrombosis. It is one of key regulatory molecules in vascular system.
仅用于科研。不用于诊断过程。未经明确授权不得转售。
篇参考文献 (0)
生物信息学
蛋白别名: adhesion molecule; CD31; CD31 antigen; EndoCAM; GPIIA'; PECA1; PECAM-1; PECAM-1 precursor; Platelet endothelial cell adhesion molecule; platelet endothelial cell adhesion molecule-1; unnamed protein product
基因别名: CD31; CD31/EndoCAM; endoCAM; GPIIA'; PECA1; PECAM-1; PECAM1
UniProt ID: (Human) P16284
Entrez Gene ID: (Human) 5175